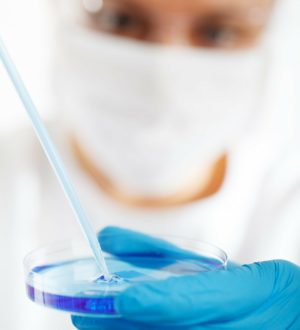
Анализ кала на яйца глист — как сдавать, результат и ход лечения

Тромбоциты в крови (PLT) — результат, расшифровка, суть анализа.

Тромбоциты в крови (Thrombocyte count — PLT) — результат, расшифровка, суть анализа
Что такое тромбоциты
Тромбоциты — клетки крови, основная функция которых — участие в свертывании крови.
Тромбоциты, как и другие клетки крови, образуются в костном мозге. Часть некоторых стволовых клеток в костном мозге превращаются в мегакариоциты, от которых тромбоциты «отщепляются» и выходят в кровь. Они лишены ядра и имеют относительно небольшой размер (2–3 микрона в диаметре).
Повреждение сосуда вызывает образование веществ, которые переводят тромбоциты в активную форму. Тромбоциты уплощаются и обретают способность склеиваться друг с другом и со стенкой сосуда, создавая тромб, который способствует остановке кровотечения. Тромбоциты выполняют ангиотрофическую, адгезивно-агрегационную функции, участвуют в процессах свёртывания крови и фибринолиза, обеспечивают ретракцию кровяного сгустка. Они способны переносить на своей мембране циркулирующие иммунные комплексы, поддерживать спазм сосудов.
Продолжительность жизни тромбоцитов — около 10 дней, поэтому требуется их постоянное обновление. Если нарушается баланс между образованием тромбоцитов в костном мозге и их разрушением, то может возникать склонность к повышенной кровоточивости или, напротив, к тромбообразованию.
В ходе анализа происходит подсчет количества тромбоцитов в единице крови — в литре или в микролитре.
При хронических миелопролиферативных синдромах тромбоцитоз является частым явлением и может служить важным патофизиологическим механизмом при инициации кровоизлияния и тромбоза.
Тромбоцитопения клинически связана с кожно-слизистыми кровотечениями от петехии до желудочно-кишечных, легочных и урогенитальных кровотечений.
Количество тромбоцитов увеличивается при подъеме на высоту, в период зимы, после интенсивной физической нагрузки, травматических повреждений.
Количество тромбоцитов снижается перед менструацией и во время беременности.
Как проводят подсчет тромбоцитов при анализе
Результат и расшифровка
Норма
Дети:
- До 1 года: 180-400.
- 1-16 лет: 160-390.
Повышены тромбоциты в крови (PLT)
- Транзиторный тромбоцитоз (мобилизация тромбоцитов из экстраваскулярного пула) — физическая нагрузка, родовая деятельность, при назначении эпинефрина.
- Первичный тромбоцитоз:
— врожденный тромбоцитоз (мутация гена, отвечающего за тромбопоэтин, в хромосоме);
— миелопролиферативные синдромы: эссенциальная тромбоцитемия, истинная полицитемия, хроническая миелоидная лейкемия, миелоидная метаплазия с миелофиброзом.
- Вторичный тромбоцитоз/реактивный:
— инфекционные заболевания, воспалительные заболевания, злокачественные заболевания, быстрое восстановление после геморрагии/гемолитической анемии, возобновление симптомов после выздоровления при тромбоцитопении, анатомическая аспления, железодефицит, после оперативного вмешательства
Понижены тромбоциты в крови (PLT)
- Повышенное разрушение тромбоцитов: наиболее распространенная причина тромбоцитопении, которая и определяет стимуляцию тромбопоэза, приводя к увеличению числа, размера и созреванию мегакариоцитов костного мозга.
- Иммунологические факторы возникновения:
— аутоиммунные (инфекции, беременность, сосудистые коллагенозы, лимфопролиферативные заболевания, злокачественные опухоли, лекарства и т.д.). При этих состояниях пусковым механизмом является наличие антитромбоцитарных аутоантител типа IgG и/или IgA, редко — IgM, которые активируют комплемент и сокращают продолжительность существования тромбоцитов;
— аллоиммунные (неонатальная тромбоцитопения, посттрансфузионная пурпура).
- Неиммунологические факторы возникновения:
— тромбоцитические микроангиопатии (ДВС-синдром, тромбоцитическая тромбоцитопеническая пурпура, гемолитический уремический синдром, при беременности (гемолиз/эклампсия, повышение ферментов печени и снижение содержания тромбоцитов));
— повреждения тромбоцитов при аномальных поверхностях сосудов (ангиопатии, атеросклероз, сосудистые протезы, катетеры, экстракорпоральная циркуляция и т.д.);
— инфекционные заболевания различной вирусно-бактериальной этиологии.
- Сниженная продукция тромбоцитов:
— мегакариоцитарная гипоплазия (миелосупрессивные медикаменты, ионизирующая радиация, апластическая анемия);
— неэффективный тромбоцитопоэз (мегалобластная анемия);
— нарушение механизма регулирования тромбопоэза (дефицит тромбопоэтина, циклическая тромбоцитопения);
— врожденные тромбоцитопении (амегакариоцитарная врожденная тромбоцитопения, тромбоцитопения с отсутствием лучевой кости, синдром Вискотта-Олдрича, макротромбоцитопения X-связанная с дизэритропоэзом и т.д.);
— приобретенная амегакариоцитарная тромбоцитопеническая пурпура.
- Анормальное распределение тромбоцитов:
— заболевания селезенки (неопластические, застойные, инфильтративные, инфекционные),
— гипотермия,
— при массивной трансфузии
Лекарственные препараты, влияющие на результат анализа
- Дипиридамол
- клиндамицин
- метилпреднизолон
- метопролол
- оральные контрацептивы
- офлоксацин
- пеницилламин
- пропранолол
- стероиды
- цефтриаксон
- цефазолин
- Азитромицин
- альфа-2 интерферон
- аминокапроновая кислота
- амиодарон
- амитриптилин
- амоксициллин
- ампициллин
- амфотерицин В
- барбитураты
- вакцина БЦЖ
- вакцина от гепатита В
- вакцина от кори
- вакцина от краснухи
- вальпроевая кислота
- ванкомицин
- винбластин
- винкристин
- гентамицин
- глибенкламид
- диклофенак
- димедрол
- доксициклин
- доксорубицин
- ибупрофен
- изосорбид натрия
- индометацин
- интерлейкин-2
- итраконазол
- клиндамицин
- ловастатин
- метилдопа
- мефенамовая кислота
- морфин
- налидиксовая кислота
- нистатин
- нитроглицерин
- нитрофурантоин
- норфлоксацин
- пенициллин
- противоопухолевые препараты
- противосудорожные
- рифампицин
- сульфонилмочевина
- тиазиды
- тобрамицин
- флуконазол
- хлорамфеникол
- цефокситин
- цефуроксим
- циклофосфамид
- эналаприл
- этакриновая кислота
- аллопуринол
Показания к назначению
- Кровотечения;
- геморрагические заболевания;
- тромбоцитарные болезни неясной этиологии;
- при установлении коагуляционного профиля;
- мониторинг заболеваний, связанных с медуллярной недостаточностью;
- мониторинг в ходе лечения, которое может вызывать медуллярную супрессию (радиация, химиотерапия и т.д.);
- входит в рутинный общий анализ крови, который проводится как планово, так и при различных болезнях и патологических состояниях, перед хирургическими вмешательствами